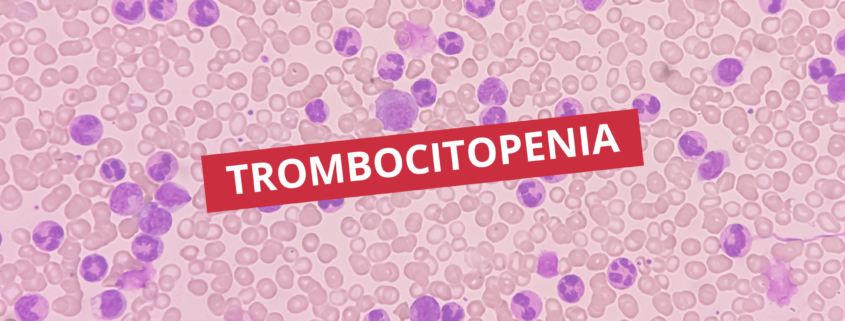

Trombocitopenia
A trombocitopenia é um achado laboratorial caracterizado pela redução do número de plaquetas no sangue periférico, geralmente abaixo de 150.000/mm³. Embora possa ser identificada como um resultado isolado em exames de rotina, sua interpretação exige análise criteriosa, pois pode refletir desde alterações benignas e transitórias até condições clínicas potencialmente graves.
Na prática laboratorial, compreender a trombocitopenia vai além de reconhecer um valor reduzido: envolve investigar mecanismos fisiopatológicos, causas associadas, possíveis interferências pré-analíticas e correlação com o contexto clínico e outros parâmetros hematológicos.
O papel das plaquetas na hemostasia
As plaquetas são fragmentos celulares derivados dos megacariócitos da medula óssea e desempenham papel essencial na hemostasia primária. Sua função principal é atuar na formação do tampão plaquetário inicial em resposta a lesões vasculares, além de participar da ativação da cascata de coagulação.
Quando há redução quantitativa dessas células, o organismo pode apresentar maior predisposição a sangramentos, especialmente em situações de maior comprometimento hematológico.
Definição laboratorial de trombocitopenia
A trombocitopenia é definida, de forma geral, por contagem plaquetária inferior a 150.000/mm³. No entanto, sua classificação pode variar conforme a gravidade:
- Leve: 100.000 a 150.000/mm³
- Moderada: 50.000 a 99.000/mm³
- Grave: abaixo de 50.000/mm³
- Muito grave: abaixo de 20.000/mm³ (alto risco de sangramentos espontâneos)
Essa estratificação é importante para avaliação de risco hemorrágico e condução clínica.
Mecanismos fisiopatológicos
A trombocitopenia pode ocorrer por três mecanismos principais:
1. Produção diminuída
Relaciona-se à falência ou supressão da medula óssea. Nesse cenário, há redução na formação de plaquetas, podendo ocorrer em condições como:
- Aplasia medular
- Leucemias e infiltrações neoplásicas
- Deficiências nutricionais (vitamina B12 e ácido fólico)
- Efeito de medicamentos mielossupressores
- Infecções virais com supressão medular
2. Destruição aumentada
Ocorre quando há aumento da degradação periférica das plaquetas, podendo ser imunomediada ou não:
- Púrpura trombocitopênica imune (PTI)
- Reações autoimunes
- Coagulação intravascular disseminada (CIVD)
- Infecções sistêmicas graves
- Uso de heparina (trombocitopenia induzida por heparina)
3. Sequestro esplênico
Caracteriza-se pela retenção aumentada de plaquetas no baço, comum em condições com esplenomegalia:
- Cirrose hepática com hipertensão portal
- Doenças hematológicas crônicas
- Esplenomegalia de diversas etiologias
Causas comuns na prática laboratorial
Na rotina de análises clínicas, algumas causas são mais frequentemente associadas à trombocitopenia:
- Infecções virais (como dengue e outras viroses sistêmicas)
- Doenças autoimunes
- Uso de medicamentos (antibióticos, quimioterápicos, heparina)
- Alcoolismo crônico
- Doenças hepáticas avançadas
- Distúrbios hematológicos primários
A identificação da causa depende da integração entre hemograma completo, histórico laboratorial e outros exames complementares.
Pseudotrombocitopenia: um falso resultado relevante
Um aspecto essencial na interpretação da trombocitopenia é a possibilidade de pseudotrombocitopenia, uma interferência analítica que simula redução plaquetária sem que haja, de fato, diminuição no organismo.
Esse fenômeno ocorre, principalmente, por aglutinação plaquetária induzida por EDTA, anticoagulante utilizado em tubos de coleta de hemograma.
Características da pseudotrombocitopenia:
- Plaquetas agregadas no esfregaço sanguíneo
- Contagem automatizada falsamente reduzida
- Ausência de sinais clínicos de sangramento
- Correção do resultado em amostra com outro anticoagulante (como citrato)
A identificação dessa condição evita diagnósticos equivocados e intervenções desnecessárias.
Abordagem laboratorial da trombocitopenia
A investigação da trombocitopenia deve seguir uma lógica analítica estruturada, considerando:
1. Confirmação do resultado
- Revisão do hemograma automatizado
- Análise do esfregaço sanguíneo
- Exclusão de agregação plaquetária
2. Avaliação do hemograma completo
- Presença de anemia associada
- Alterações em leucócitos
- Índices hematimétricos relevantes
3. Análise do contexto clínico-laboratorial
- Infecções recentes
- Uso de medicamentos
- Doenças hepáticas ou autoimunes
- Histórico hematológico
4. Exames complementares
- Função hepática e renal
- Sorologias virais
- Marcadores inflamatórios
- Avaliação de medula óssea, quando indicado
Trombocitopenia e risco hemorrágico
A gravidade clínica da trombocitopenia não depende apenas da contagem de plaquetas, mas também da sua funcionalidade e da presença de outros distúrbios hemostáticos.
Em geral:
- Acima de 50.000/mm³: risco baixo de sangramento espontâneo
- Entre 20.000 e 50.000/mm³: risco moderado, especialmente em traumas
- Abaixo de 20.000/mm³: risco elevado de sangramento espontâneo
Manifestações clínicas podem incluir petéquias, equimoses, sangramento gengival e epistaxe.
Interpretação crítica no laboratório clínico
A trombocitopenia deve ser interpretada como um sinal laboratorial e não como diagnóstico isolado. Sua relevância está na capacidade de orientar investigações mais amplas, exigindo correlação com dados clínicos e outros parâmetros hematológicos.
Além disso, fatores pré-analíticos e interferências técnicas desempenham papel fundamental na confiabilidade do resultado, tornando essencial a análise criteriosa de cada etapa do processo laboratorial.
A trombocitopenia representa uma alteração hematológica frequente na rotina laboratorial, com ampla diversidade etiológica e diferentes níveis de gravidade. Sua interpretação adequada depende da integração entre mecanismo fisiopatológico, avaliação laboratorial detalhada e exclusão de interferências analíticas.
Mais do que um número reduzido no hemograma, trata-se de um marcador que exige raciocínio crítico e abordagem sistemática para garantir precisão diagnóstica e evitar interpretações equivocadas.
Na Pós-graduação em Análises Clínicas e Medicina Laboratorial da Cursau, você desenvolve raciocínio clínico-laboratorial avançado para interpretar exames com precisão, segurança e visão integrada da prática profissional.